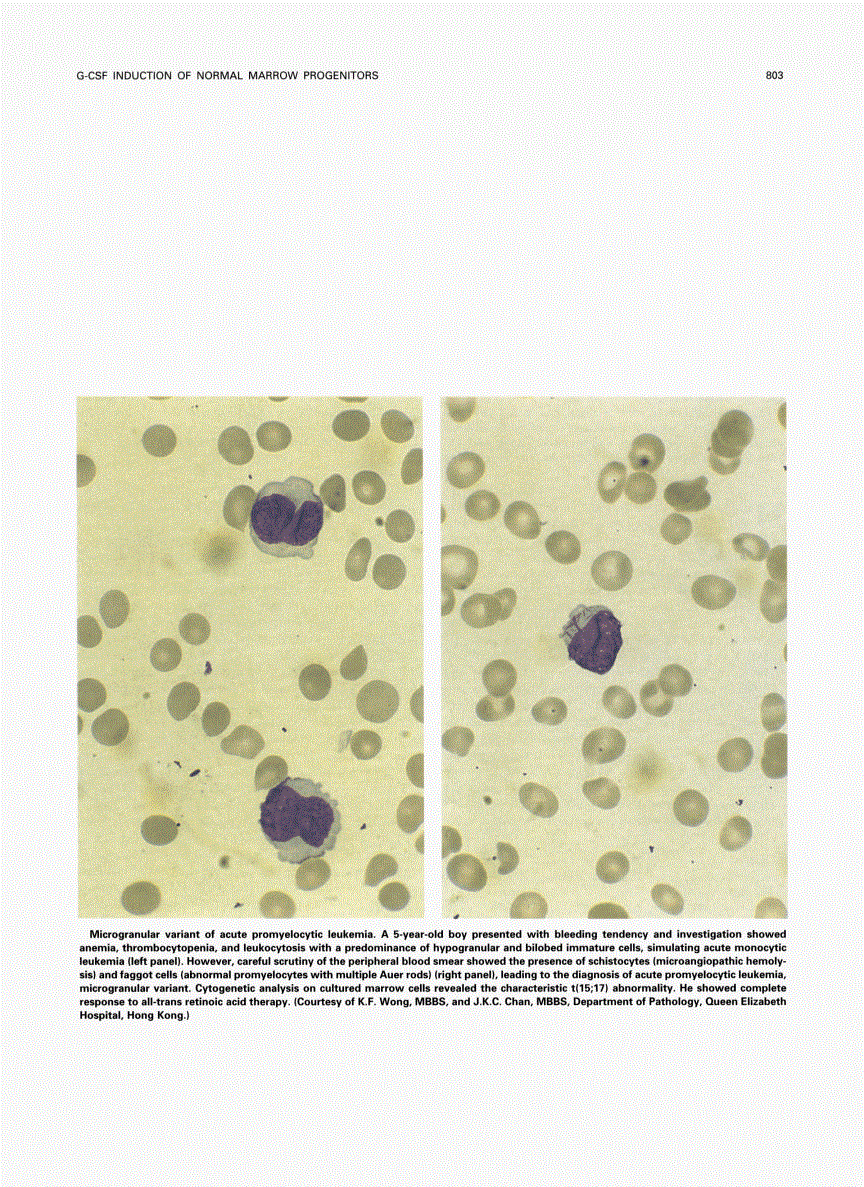

Skip Nav Destination
PHOTOGRAPHS|
February 1, 1995
Citation
K. F. Wong, JKC. Chan; Photograph. Blood 1995; 85 (3): 803. doi: https://doi.org/10.1182/blood.V85.3.803.803
Download citation file:
February 1 1995
Advertisement intended for health care professionals
Cited By
Advertisement intended for health care professionals

This feature is available to Subscribers Only
Sign In or Create an Account Close Modal